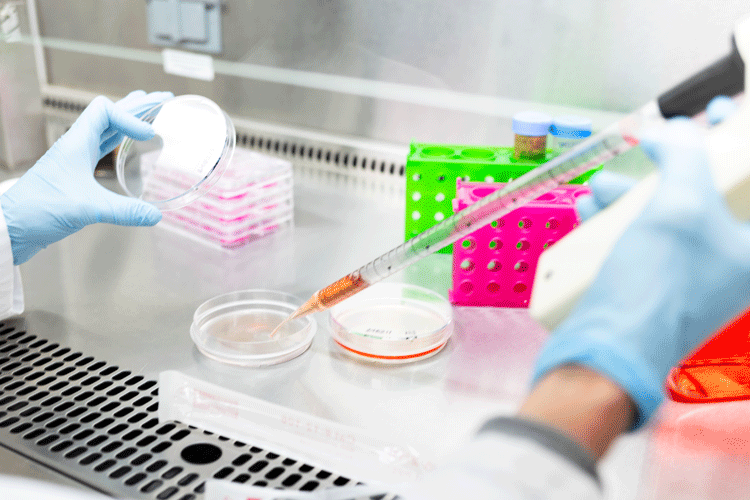
Protein and chemical analysis

Find a research core, service, or resource
To return to the shared facilities home page, click here.
Facility and resource categories
Animal research

Bioinformatics and statistical analysis services

Cell analysis

Clinical research support

Education and training

Engineering and fabrication services

Field stations and vessels

Imaging and visualization

Information and data science services

Large-scale testing and testbeds

Materials and chemical analysis

Protein and chemical analysis
Qualitative and quantitative survey research

Research computing and data storage

Sequencing and gene expression analysis
